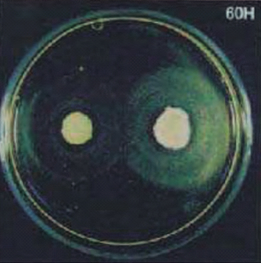

Saltose
PACKING; 20KG / BAG
New Probiotics & Strong Enzyme Combination
Our Bacillus bacteria which are screened among 10,000 strains and special enzymes ensure the safety and health of poultry and livestock by controlling harmful bacteria (Salmonella, E. coli, Clostridium) and parasites (Coccidium, Cryptosporidium)
PIC-BIO INC. has been involved in research and development of remedies for not only production of antibiotic-free poultry and livestock but also enzyme products that are capable of preventing migration of zoonotic diseases as replacement of antibiotic for number of years since PIC-BIO INC. was incorporated.
One of the enzyme products is "SALTOSE" by its trade name whose efficacy has been recognized by poultry and livestock industries in Japan and foreign countries.
What is SALTOSE?
SALTOSE is one of leading probiotics which contains Bacillus group, Enterococcus group and unique enzymes. SALTOSE can prevent and treat the bacterial and parasitic diseases with the characteristics of used bacteria and enzymes, and improve the productivity for poultry and livestock.
Ingredients and Characteristics
We have selected 5 strains of Bacillus group among more than ten thousand strains of Bacillus group which do not produce antibiotics, but produce unique enzymes which can break down the cell wall of bacteria and oocyst of some important parasites.
| The Bacillus group; 1.Bacillus licheniformis 2.Bacillus subtilis 3.Bacillus pumilus |
|
| The main enzymes; 1.Beta-Xylanase 2.Cell-Wall Lyase 3.Protease |
The Enterococcus group; 1.Enterococcus faecalis 2.Enterococcus faecium |
|
Lysis Effects on Eggs of Parasites or Oocysts 2 - 1
Coccidium oocyst (Poultry)
Before SALTOSE |
After SALTOSE |
Coccidium oocyst germinated and sporocyst developed |
Coccidium oocyst was dissolved completely and its original shape disappeared. |
Coccidium oocyst (Cattle)
Before SALTOSE |
After SALTOSE |
Coccidium oocyst germinated and sporocyst developed. |
Coccidium oocyst was dissolved completely and its original shape disappeared. |
Lysis Effects on Eggs of Parasites or Oocysts 2 - 2
Cryptosporidium (Cattle)
Prepared culture media for SALTOSE and inoculated Cryptosporidium for observation of degradation effects.
Before SALTOSE application |
|
After 12 hours |
Finally, Cryptosporidium was dissolved completely and its original shape disappeared.
Inhibitory Effects on Bacteria 2 - 1
Salmonella Enteritidis

Prepared culture media for S.Entertidis and inoculated the follwing bacteria.
| 1, 6, 7, 8, 9 : SALTOSE T : Competitor C : Competitor S1 : S.Typhimurium S2 : S.Gallinarum |
SALTOSE shows their antibacterial activities with the formation of inhibition ring.
Salmonella Enteritidis and Salmonella Gallinarum
RL bacteria were inoculated in YM-SE and YM-SG culture medium for observation of inhibition ring.
|
|
| YM : Yeast and Malt RL : SALTOSE bacteria SE : S.Enteritidis SG : S.Gallinarum SP : other Bacillus subtilis |
- SALTOSE produced a large inhibition ring, which indicates strong control effect on S.Enteritidis and S.Gallinarum
- Other Bacillus subtilis indicated almost no control effect.
Inhibitory Effects on Bacteria 2 - 2
Clostridium
Prepared culture medium for Clostridium and inoculated Bacillus licheniformis of SALTOSE (Right side) and the other Bacillus licheniformis (Left side) bacteria for observation of growth and inhibition ring.
12 hours |
32 hours |
60 hours |
Graph for Right side |
32 hours after the inoculation, Bacillus licheniformis of SALTOSE stopped their growth due to completing the absorption of nutrients from culture medium.
However, inhibition ring continued to expand, and dissolved Clostridium.
Antagonistic Effects on Bacteria 3 - 1
Salmonella Enteritidis(840) and Salmonella Infantis (837)
Competitor |
SALTOSE |
| Competitor did not absorb the inoculated Salmonella bacteria. | SALTOSE absorbed the inoculated Salmonella bacteria. |
Antagonistic Effects on Bacteria 3 - 2
Salmonella Gallinarum
S.Gallinarum were inoculated in DP (Left side) and YM (Right side) culture medium, and then, each bacterium was inoculated in the same point for observation of antagonistic effects.
|
|
| DP : Dexton and Pepton SE : S.Enteritidis RL : SALTOSE bacteria SP : Other Bacillus subtilis YM : Yeast and Malt SG : S.Gallinarum |
- The growth power of SALTOSE bacteria is the strongest, and SALTOSE bacteria controls S.Gallinarum bacteria.
- Other Bacillus subtilis indicated poor growth power.
Antagonistic Effects on Bacteria 3 - 3
E. coli (K-88)
![]() |
![]() |
E. coli (K-88) and SALTOSE bacteria were inoculated on the same culture medium. It is observed that SALTOSE shows more antibacterial activities against E. coli .
Useful Bacteria (Lactic acid bacteria and Bifido bacteria)
Lactic acid bacteria |
Bifido bacteria |
SALTOSE did not damage the useful bacteria.
The Other Data
Testing result (Excreta of poultry)
1. Reduction of generating ammonium odor
![]() |
Generation of ammonia from broiler farm was reduced due to application of SALTOSE. |
2. Comparison of digestibility
![]() |
S: SALTOSE Result: SALTOSE treatment can improve the digestion, so the amount of undigested materials in the excreta becomes half as compared with the control. |
3. Bacterial 1 count in the excretion of chickens
![]() |
The count of Bacillus bacteria in the excretion remained almost unchanged; however, the total bacteria count was reduced as dosage rate was increased. |